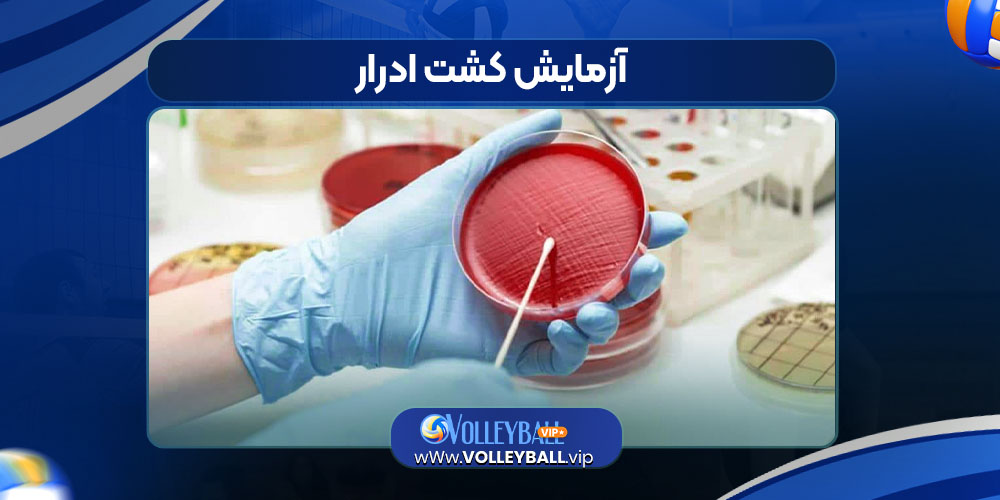

آزمایش کشت ادرار
آزمایش کشت ادرار یک روش تشخیصی مهم برای شناسایی عفونتهای ادراری است. در این آزمایش، نمونه ادرار در شرایط استریل جمعآوری شده و روی محیط
آزمایش کشت ادرار یک روش تشخیصی مهم برای شناسایی عفونتهای ادراری است. در این آزمایش، نمونه ادرار در شرایط استریل جمعآوری شده و روی محیط

بیماری مرس یا سندرم تنفسی خاورمیانه (MERS) یک عفونت ویروسی جدی در دستگاه تنفسی است که نخستین بار در سال ۲۰۱۲ در کشور عربستان سعودی

قرص لومیدکس (LOMIDEX) با نام ژنریک لوپرامید یک داروی ضد اسهال پرمصرف است. این دارو با کند کردن حرکات روده، باعث کاهش دفع آب و

بافت همبند یا همان بافت پیوندی، وظیفه اصلیاش ایجاد انسجام در بدن است و با فراهم کردن استحکام و فرم، به اندامها و عضلات شکل

نوروپاتی به مجموعه اختلالاتی گفته میشود که در آن اعصاب محیطی بدن آسیب میبینند یا عملکرد طبیعی خود را از دست میدهند. اعصاب محیطی وظیفه

بیماری تریکوتیلومانیا (Trichotillomania) یا اختلال کندن مو یکی از اختلالات روانشناختی است که در دستهی اختلالات وسواس فکری-عملی (OCD related disorders) طبقهبندی میشود. در ادامه مطلب با وب سایت

سریال ایرانی «وحشی»، یک اثر درام–جنایی پرتنش است که داستان شخصیتهایی پیچیده و درگیر با مسائل زندگی و تصمیمات سخت را روایت میکند. این سریال

رپرها معمولاً در شهرهای بزرگ و مراکز موسیقی زندگی میکنند، مثل لسآنجلس، نیویورک، آتلانتا در آمریکا و لندن، پاریس در اروپا.رپرهای ایرانی بیشتر در تهران

جیمز کامرون، کارگردان افسانهای فیلمهای «تایتانیک» و «آواتار»، با موفقیتهای سینمایی خود رسماً به جمع میلیاردرهای هالیوود پیوست. در ادامه مطلب با وب سایت مجله خبری

شارلیز ترون بهعنوان سفیر جدید جواهرات «لا رُز دیور» انتخاب شد و جلوهای تازه به این مجموعه لوکس بخشید. در ادامه مطلب با وب سایت
مجله خبری والیبال پایگاه تخصصی اخبار، تحلیلها و ویدیوهای داغ والیبال ایران و جهان.
با ما همراه باشید برای پوشش زنده مسابقات، معرفی ستارهها و حواشی جذاب دنیای والیبال.
به پنل کاربری خود وارد شوید